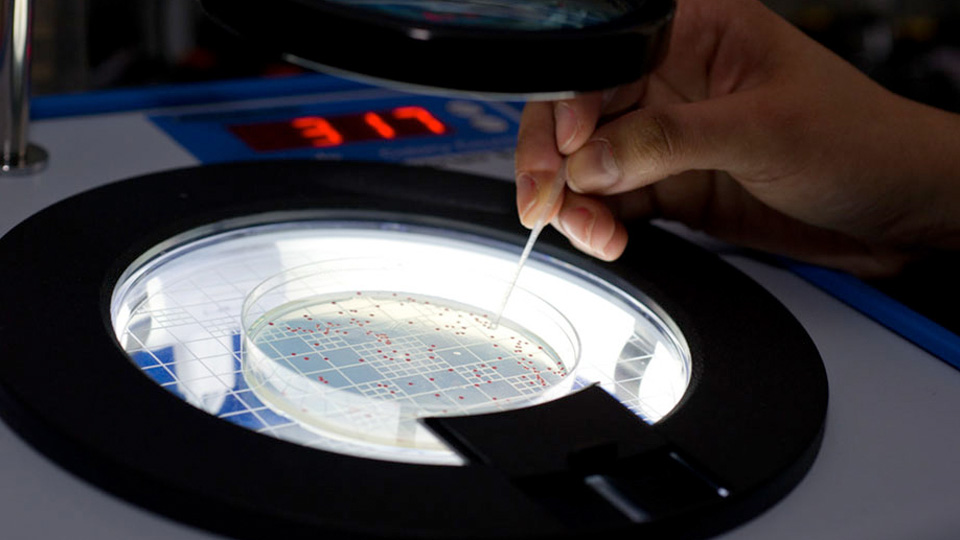
A hand uses a tool to count or isolate colonies in a petri dish placed on an illuminated colony counter.

Explore Our Core Facilities
IBB's state-of-the-art research facilities, known as Core Facilities, serve as a shared resource for the bioengineering and bioscience community. Consultation, training, and technical support are available for a variety of research projects.
IBB administers Core Facilities in several buildings across the Georgia Tech campus that are fully staffed by highly qualified personnel. Research professionals are available to support the activities of Georgia Tech researchers, as well as external academic investigators and companies. If you have any questions, please email coreinfo@ibb.gatech.edu.
Core Facilities

3D Printing
The 3D Printing Core offers advanced PolyJet 3D printers, combined with AI-assisted medical image segmentation, fabricate realistic anatomical models enhanced by a proprietary algorithm that mimics tissue mechanics. With applications in New Alternative Methods (NAMs) for medical device testing, surgical planning, patient education, and medical training, our team provides expert support to researchers, clinicians, and industry partners.

Advanced Bioinformatics
The Advanced Bioinformatics Core uses sophisticated computational and statistical methods to analyze complex biological data, such as large-scale genomic, transcriptomic and proteomic datasets, to gain deeper insights into diseases, drug discovery and fundamental biological processes.

Biomechanics
The Biomechanics Core offers tension and compression testing for different scales of specimens ranging from soft hydrogels to metal bone implant components. A servo-hydraulic system (MTS MiniBionix) and an electromechanical (TA 3200) test platform support tension, compression, and torsion testing of a range of forces, with a TA3100 system capable of forces as low as 1N (tension/compression). Additionally, a MCR302e rheometer from Anton-Paar allows extensive rheological testing at temperatures up to 200 degrees Celsius with cone plate, parallel plate, and sand-blasted parallel plate measuring tools to allow evaluation of fluids to ultra soft hydrogels. Further, the rheometer also has measuring tools adapted for torsion testing of small specimens, as well as tensile testing of thin films.

Biomolecular Analysis
The Biomolecular Analysis Core provides tools that enable researchers to identify, characterize, and quantify molecules of life, such as DNA, RNA, proteins, lipids, and carbohydrates, using various scientific techniques. This interdisciplinary field provides crucial data for understanding biological processes, developing medical diagnostics, and creating new therapies. Key techniques include spectroscopy, chromatography, and electrophoresis, which help determine molecular structure, detect interactions, and assess purity and quantity.

Biopolymer Characterization
The Biopolymer Characterization Core specializes in the analysis of mostly naturally occurring polymers such as DNA, proteins, and carbohydrates. Multiple techniques are used, such as differential scanning fluorimetry, differential scanning calorimetry, size exclusion chromatography with multi-angle light scattering, and spectrometry.

Cellular Analysis and Cytometry
The BD Accuri, Fortessa, and the Cytek Aurora provide spectral detection and the Beckman Coulter Cytoflex cytometers come with plate loaders and provide analysis. The BD FACS Aria IIIu and Melody provide fluorescence-activated cell sorting. The Amnis Imagestream X can provide image data for samples with large populations of cells. The core has extended its analysis capabilities with the addition of imaging mass cytometry (Hyperion Tissue imaging system) with the traditional mass cytometry (Helios CyTOF).

Genome Analysis
The Genome Analysis Core uses precision characterization of genomes and phenotypes across microbes to mammalian cells. Services include 16S/18S/ITS profiling, targeted & whole-genome sequencing, human leukocyte antigen typing, monoclonal antibody sequencing, genome-editing validation, copy number variation analysis, single-cell RNA/DNA sequencing, quantitative polymerase chain reaction (qPCR) and digital polymerase chain reaction (dPCR) assay design and validation, and enzyme-linked immunosorbent assay (ELISA).
High-Throughput Sequencing
The High-Throughput Sequencing Core provides comprehensive sequencing support from small panels to full genomes. Platforms include Illumina, Oxford Nanopore, and Elements Bioscience. End-to-end services include: library prep, custom indexing, run optimization, and bioinformatics support (Geneious, Qiagen CLC).

Histology
While the core provides efficient, high-quality service for routine samples, our expertise lies in the precise handling and analysis of non-routine and esoteric tissues. Equipped with state-of-the-art instrumentation, we ensure successful processing and analysis across all matrices — fresh, frozen, paraffin, agarose, gelatin, and resin—delivering reliable results from start to finish. Researchers have the flexibility to collaborate directly with our staff for full-service support or receive comprehensive training to execute work independently within the core. We specialize in traditional and custom fixation, processing, sectioning, and staining techniques to yield high-quality, innovative data to satisfy your advanced imaging needs.

Magnetic Resonance Imaging (MRI)
The MRI core operates a 7T pre-clinical MRI scanner designed for pre-clinical using advanced MRI techniques. The core frequently supports Biomedical research such as the development of new contrast agents. The MRI core facility is actively involved in hardware developments focusing on the combination of MRI with other techniques such as Ultrasound.

Microcomputed Tomography
MicroCT core has two specimen scanners and two dedicated in vivo scanners. The Scanco uCT50 is equipped with a multi-sample carousel that allows batch scans of up to 12 specimen holders. The system is capable of nominal resolutions from 1.2um to 48um using the appropriate specimen holders. Additionally, a force sensor equipped holder allows tension and compression of specimens on board, to provide pre- and post-deformation scans. The MicroCT core also hosts an IVIS Spectrum CT and an IVIS Spectrum-2 units for fluorescence and bioluminescence imaging with or without CT overlay. Image data analysis is also supported using Materialise Mimics, Dragonfly, and Imaris imaging suites.

Molecular Evolution Core Laboratory (MECL)
MECL provides expertise in large-scale library construction and characterization for evolutionary experiments. We also support custom cloning and display platforms (phage, yeast, and bacterial), plus in-house oligonucleotide and peptide synthesis. A CLIA certified lab within MECL designs and runs high-complexity tests for the Georgia Tech community.

Optical Microscopy
The Optical Microscopy Core provides researchers with advanced imaging technologies, expert training, and personalized support. Our diverse suite of microscopes, including several that are the only ones of their kind in the region, empowers discoveries from nanoscale structures to dynamic live-cell imaging.

Stem Cell
UCLA’s Stem Cell Core, in partnership with Georgia Tech, provides end-to-end CRISPR genome engineering, advanced pluripotent stem cell characterization and differentiation, and induced pluripotent stem cell (iPSC) reprogramming services. We support high-quality stem cell research through validated, reproducible workflows and collaborates with academic and industry partners to advance studies in development, disease modeling, and regenerative medicine.

Systems Mass Spectrometry-Metabolomics (SyMS-M)
The mission of SyMS-M is to provide state-of-the-art analytical measurements that support modern metabolomics as well as molecular analysis. Our team of expert scientists is committed to innovation and collaborative partnerships to advance molecular insights in a variety of research projects.

Systems Mass Spectrometry - Proteomics (SyMSC-P)
SyMS-P is dedicated to accelerating transformative research by providing cutting-edge proteomics capabilities. Powered by state-of-the-art LC-MS systems and a team of expert scientists, SyMS-P delivers comprehensive solutions, from experimental design to data analysis. Through scientific excellence, innovation and collaborative partnerships, SyMS-P empowers researchers to unravel proteome complexities, advancing breakthroughs in biology, medicine and biotechnology.
Image Data Analysis Services
IBB provides guidance and support for basic image reconstruction and 3D quantitative analysis workflows for MicroCT, MRI, and microscopy image stacks. Upon request, high content image analysis for unsupervised processing of 2D images primarily from Hyperion or similar high content biomarker imaging system is provided.
Contact Laxmi Krishnan
Core Facilities Contact
For questions and inquiries, please email coreinfo@ibb.gatech.edu
